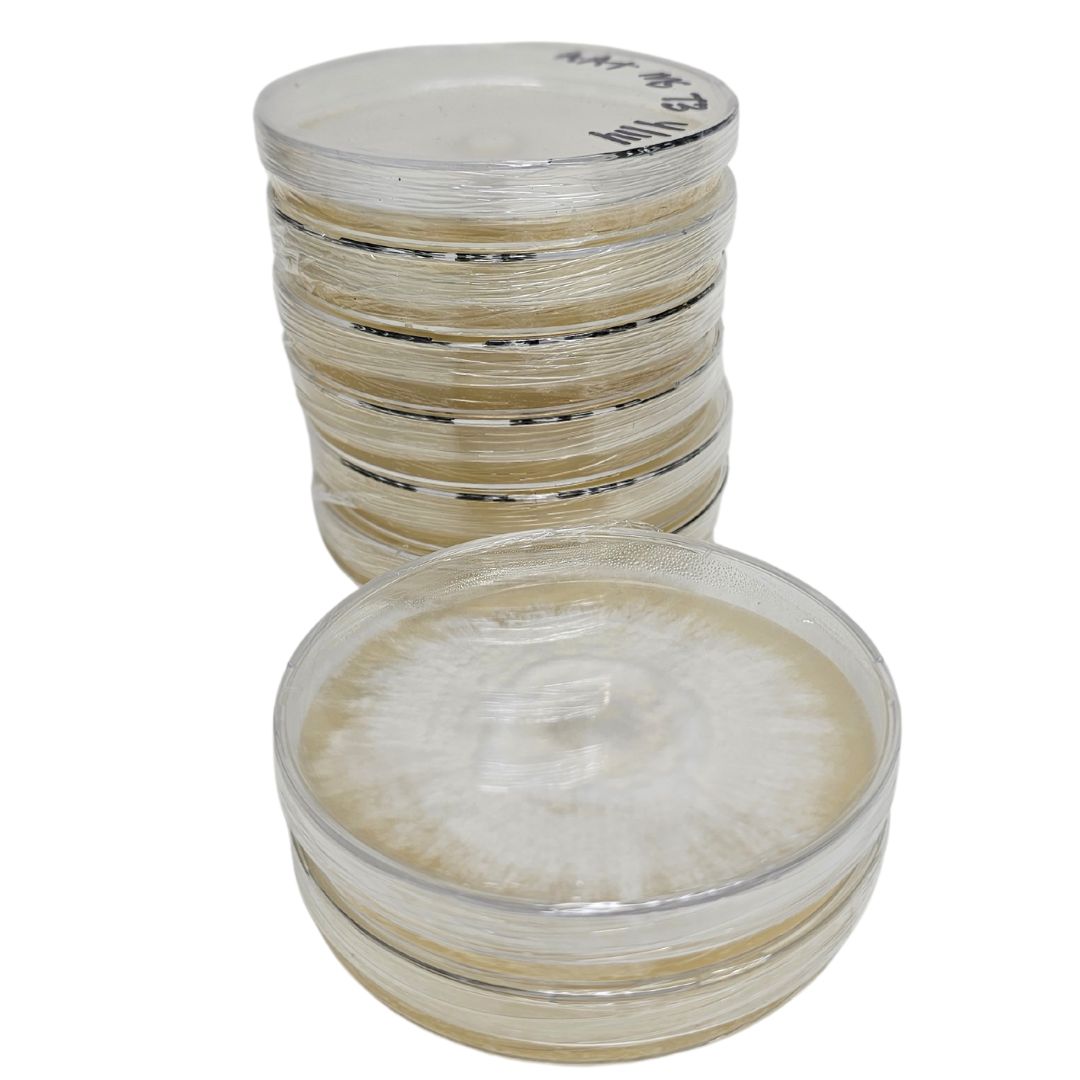
Pre-poured Agar Plates (10 pack) - Image 2

Pre-poured Agar Plates (10 pack)
$18.79
Malt Extract Agar Plates for Spore Germination and Contamination Detection
High-quality Malt Extract Agar Plates, pre-poured and ready for mycology and fungal cultures. Perfect for reliable and consistent results.
- Lab quality agar plates
- Malt Extract Agar (MEA)
- Sterile and ready to use
Description
Ready to use agar plates for fungal growth and contamination detection.
Our pre-poured Agar Plates are the ideal choice for mycologists and researchers looking for high-quality, pre-poured agar dishes. Made with premium malt extract, these agar plates are specifically designed to support the growth and cultivation of a wide range of fungi, including yeasts and molds. Each plate is prepared under sterile conditions to ensure contamination-free experiments and consistent, reliable results.
Key Features:
- Pre-poured Convenience: Ready-to-use plates save you time and effort.
- Premium Quality: Made with high-quality malt extract for optimal fungal growth.
- Sterile and Reliable: Prepared under strict sterile conditions for contamination-free results.
- Versatile Applications: Suitable for various mycological and fungal research purposes.
- Consistent Results: Ensures reliable outcomes in your experiments.
Perfect for educational institutions, research laboratories, and hobbyist mycologists, our Malt Extract Agar Plates are your go-to solution for successful fungal cultivation. Enhance your mycology projects with these top-quality, pre-poured agar dishes and achieve the best results every time.

Reviews
There are no reviews yet.